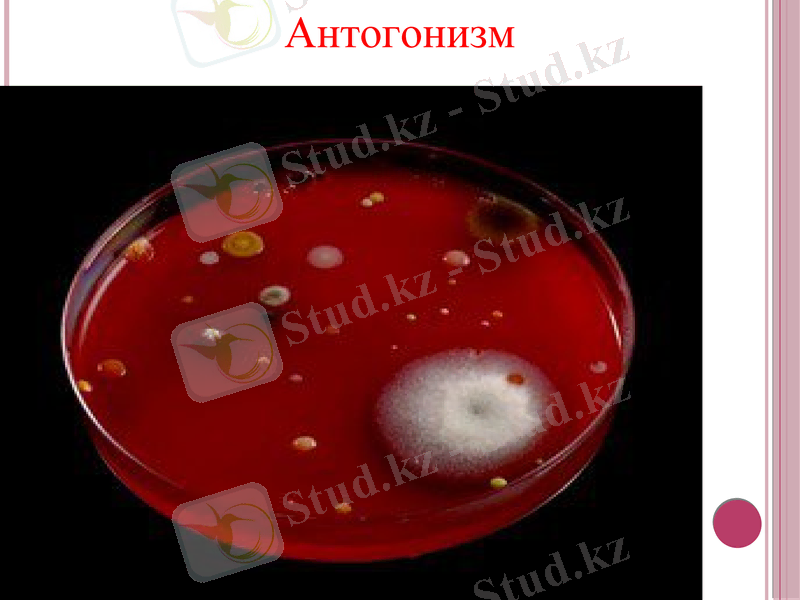
Slide 20

Микроорганизмдердің өзара қарым-қатынастары: симбиоз, метабиоз, сателлизм, синергизм, антогонизм, вирогения, мутуализм, паразитизм және комменсализм



Қазақстан Республикасы Білім және Ғылым Министрлігі Семей қаласының Шәкәрім атындағы Мемлекеттік университеті.
БӨЖ №3 Тақырыбы: Микроорганизмдердің өзара қарым - қатынасы. Симбиоз, метабиоз, сателлизм, синергизм, антогонизм, вирогения, мутуализм, паразитизм және комменсализм. Орындаған: Кәрімова Е. Тексерген: Омарбеков Е. О.
Топ: Бл - 309. Семей 2015

Жоспар:
Микроорганизмдердің өзара қарым - қатынастары
Симбиоз
Метабиоз
Сателлизм
Синергизм
Антогонизм
Вирогения
Мутуализм
Паразитизм
Комменсализм
Пайдаланылған әдебиеттер

Микроорганизмдердің өзара
қарым - қатынасы
Биоценозда әр түрлі түрлер арасында белгілі бір қарым-катынастар қалыптасады. Оның негізі қоректік тізбектерге байланысты екені белгілі. Десе де, организмдер арасындағы кеңістік қарым-катынастар да негізгі рөл атқарады. Қоректік тізбектер өсімдік, құстар мен жануарлар арасында болды. Табиғатта ешқандай шекара жоқ, онда бәрі де бір - бірімен байланысты және өзара тәуелді болып келеді. Тіршілік иелері тұрақты экологиялық жүйеге - биоценоздарға біріктірілген. Олардың әрқайсысы үшін популяцияның түрлік және сандық қатынасы, құрылым, өзара қатынас және басқа да белгілер тән. Әртүрлі ценоздардың ішінде табиғатта микробоценоздар - микроорганизмдердің қауымдастығы үлкен орын алады. Олардың және басқа тірі организмдердің арасында алуан түрлі өзара қатынастар бар. Бұл қатынастар Симбиоз, метабиоз, сателлизм, синергизм, антогонизм, вирогения, мутуализм, паразитизм, комменсализм және басқа түрлерде байқалынады.



Нейтрализм - биотикалық қарым-қатынастың бiр түрi. Бұл қатынаста бiр территорияда тiршiлiк ететiн екi түр бiр-бiрiне зиянын да, пайдасын да тигiзбей өмiр сүредi. Нейтрализмде түрлер бiр табиғи бiрлестiкте өмiр сүрсе де, бiр-бiрiмен байланыспайды. Мысалы, бiр орманда тiршiлiк ететiн тиiн мен бұғының тiршiлiгi мүлдем байланыспайды. Нағыз нейтрализм табиғатта өте сирек кездеседi, себебi кез - келген экожүйеде барлық популяциалардың арасында жанама әрекеттесулер болады.

Симбиоз. Екі түрге жататын организмдердің кеңістікте бір-біріне ешбір зиянын тигізбей, керісінше, селбесіп, пайдалы тіршілік етуі симбиоз деп аталады. Мысалға, тақуа шаян мен актиния арасындағы селбесуді, сондай-ақ балдыр мен саңырауқұлақтың селбесуі нәтижесінде қыналардың тіршілік етуін келтіруге болады.

Симбиоз терминін 1879 ж. неміс ботанигі А. Де Бари (1831-1888) ұсынды. Симбиоз жануарлар мен өсімдіктер арасында жиі байқалады. Организмдер үшін бірігіп тіршілік ету жеке-жеке тіршілік етуге қарағанда анағұрлым пайдалы. Олардың қоршаған ортамен қарым - қатынасы және одан келетін пайдасы осы симбиоз арқылы қалыптасады.

организмдер бір - бірімен симбиоз құрғанымен, әрқайсысының жеке тіршілік ете алуы. Мысалы: үйеңкі ағашы қарағай мен балқарағайдың жақсы өсуіне әсер етеді.
симбиоз құрған екі организмнің бір - бірінсіз тіршілік ете алмауы. Мысалы: бірі болмаса, екіншісі тіршілік ете алмайтын саңырауқұлақ пен балдыр симбиозы - қына. Мұнда балдыр саңырауқұлақты фотоцинтез процесінде түзілетін органик заттармен қамтамасыз етіп, өзі одан минералды заттар, су алады. Симбиоз жануарлар арасында да жиі кездеседі. Мысалы: термиттер мен құмырсқалар қоңыздар мен симбиозды тіршілік етеді.
Облигатты түрі
Факультативті түрі


Кооперация
симбиоз түрі, бірігіп өмір сүрудің тиімділігі, бірақ бірігіп өмір сүрушілер үшін міндетті емес.

Кооперация

Симбиоз

Метабиоз-біреуі екіншісінің тіршілік өнімін пайдаланатын микроорганизмдердің өзара қатынасы. Метабиоз - микроағза түрлері арасындағы, олардың бір түрінің тіршілік өнімдері, екіншісінің қорек көзіне айналуымен сипатталатын, олардың өзара қатынастық қалыптары. Метабиозға нитрифицирлеуші бактериялар өздеріне қажетті аммиакты-аммонифицирлеуші топырақтық бактерияның тіршілік өнімін алатын симбиоз жатады.
Метабиоз - микробтың бір түрі екіншісінің өмір сүруі барысында түзілетін өнімдерді пайдаланып, олардың өсуі үшін қолайлы жағдай тудырады. Нитрификаторлар шіру микробтарының тіршілік ету барысында бөлетін өнімдерін аммиакқа дейін тотықтырады, ал азотобактер клечатка ыдырағанда түзілетін органикалық қышқылдарды қоректік зат ретінде пайдаланады.
Метабиоз


Сателлизм - бір микроорганизмнің тіршілік әрекетінің нәтижесінде түзілген өнімдері екінші микроорганизмнің өсуін ынталандырып, оған серіктес болуы. Азотобактериялар бөлетін витаминдер және басқа биологиялық белсенді заттар органикалық фосфорды бейорганикалыққа түрлендіретін микробтардың өсуіне қолайлы жағдай тудырады. Ал бұл өз кезегінде жоғары сатыдағы өсімдіктердің дамуын қамтамасыз етеді. Дәл осындай әсерді В тобының витаминдерін өндіретін ашытқылар басқа микробтарға тигізе алады.
Сателлизм

Синергизм

Синергизм - қауымдастықтағы физиологиялық функциясының күшеюі. (сүтқышқылды микроорганизмдер мен ұйытқыларда қышқыл түзуші және аромат түзушілердің бірлесіп тіршілік етуі) . Синергизм - химиялық заттектердің өзара қарым - қатынасының нәтижесінде бірлесіп жасаған әрекеті. Мысалы, екі заттектің бірлесіп жасаған әсері олардың жеке - жеке жасаған әсерінен анағұрлым әсерлі болады. Демек, синергизм жүйе элементтерінің байланысын күшейтеді. Кейбір орман ауруларымен ластағыштарды осы синергизм нәтиесінде туындаған деуге болады.

Синергизм - әртүрлі микробтық ассоциацияларға жататын түрлерде байқалатын, нәтижесінде соңғы өнімнің мөлшері көбейетін (Bac. mycoides пен азотобактерияларды бірге өсіргенде өсімдіктердің өсуін қолдайтын - гетероауксин көбейеді. ) бірдей физиологиялық процесс.
Антогонизм

Антогонизм (rp. antagonisma-күрес) - қауымдастықтың бір өкілі екіншісінің өсуін жартылай немесе толықтай тежеуі. Антогонистік өзара қатынас немесе антагонистік симбиоз, бір микроб басқасына қолайсыз әсер етіп, оның зақымдалуына, тіпті жойылуына әкеледі. Антогонист -микроорганизмдер топырақта͵ суда және адам организмі мен жануарларда кең таралған. Адамның тоқ ішегінің қалыпты микрофлорасының өкілдері-бифидобактериялар, лактобактериялар, ішек таяқшаларының және т. б. бөгде және шіріткіш микрофлораға қарсы антагонистік белсенділігі жоғары. Антогонистік өзара қатынастың механизмі әртүрлі. Антогонизмнің кең таралған түрі-микроорганизмдердің арнайы зат алмасу өнімдері-антибиотиктер түзуі, ол басқа микроорганизмнің дамуын тежейді. Антагонизмнің басқа көріністері де бар, мысалы, жылдам көбею, бактериоциндер, соның ішінде колициндер өндіру, органикалық қышқылдар өндіру және ортаның рН-ын өзгертетін өнімдерді түзу т. б. Антагонизм негізінде қорек көзіне бәсекелестік түрінде дамуы мүмкін˸ антагонист микроорганизм үдемелі дамып, қоректік заттарды азайту арқылы басқа микробтардың өсуін тежейді.

Антогонизм - бір микробтың өнімі екінші микробтың тіршілік етуіне кері әсерін тигізетін қарама - қайшы қарым - қатынас. Шіру микробтары бір ортада сүт қышқылды бактериялармен өмір сүре алмайды, өйткені сүт қышқылы рН - ты төмендетіп, алкофилдік микроорганизмдердің өсуін тежейді. Сүрлеп дайындау, ашыту, сүт қышқылды өнімдерді дайындау мен сақтау процестері осыған негізделген. Микробтардың арасындағы антогонизм табиғатта өте кеңінен таралынған. Адам микроорганизмдердің осы қасиетін әртүрлі аурулардың қоздырғыштарымен күресте пайдаланады.

Вирогения - бұл вирустар (фагтар) мен кейбір бактериялардың, ашытқылардың, қарапайымдылардың бірігіп тіршілік етуі. Микробтық клеткаға енген фаг клетканы лизиске ұшыратпайды. Клетка фагтың тасымалдаушы бола отырып, өз тіршілігін жалғастырады.
Вирогения

Мутуализм
Мутуализм (латын тілінде mutuus - өзара) - әр текті жануарлардың өздерінің сыртқы ортамен байланысын бір-бірінсіз атқара алмауы; симбиоздың бір түрі. Мутуализм кезінде екі жануардың бір-бірімен тығыз байланыста болатыны соншалық, олар бір-бірінсіз тіршілік ете алмайды. Мысалы, термиттер организміне келіп түскен қоректік зат - клетчатканы, өздерінің ішегінде, тіршілік ететін талшықтылар болмаса, қорыта алмайды.

Мутуализмнің тағы бір түрі күлдіргіш балықтар мен актиниялардың симбиозы болып табылады. Басында балықтар актинияның сырты қапталған сілекейдің нақты құрамын білу үшін және өздерін шағуға мүмкіндік беру үшін актинияға сәл тиеді. Ол сілекей актинияға өзін - өзі шағып алмау үшін қажет. Кейін күлдіргіш балық осы құрамды жаңғыртады және осыдан кейін жауларынан актинияның қармалауыштарының арасында тығыла алады. Күлдіргіш балық актинияны күтеді: суды тазартады және қорытылмаған тамақтың қалдығын алып кетеді. Балықтар «өзінің» актинияларынан алысқа ұзамайды. Арландар одан арландарды, мекиендер мекиендерді қуады. Аумақтық тәртіп, контрасты өңнің себебі болған тәрізді.
Бір организмнің екінші организмнің ішінде тіршілік етуі - мутуализмнің ең тығыз формасы болып табылады. Осының таңғаларлық мысалы ретінде сиырдың және басқа да күйісті жануарлардың ас қорыту жүйесін келтіруге болады.

Паразитизм

Паразитизм -екі әр түрлі организмдердің антагонистік қарым қатынасының формасы, мұнда біреуі екінші организмді тіршілік ортасы, қорек ретінде пайдаланады. Паразиттер қожайын организмдердің санының реттелуінде, кей жағдайда микроэволюциялық процестің бағытталуында да үлкен рөл атқарады. Паразиттер облигатты (міндетті) және факультативті (міндетті емес) болып ажыратылады. Сыртқы ортаның жағдайына байланысты микроорганизмдер өздерін паразит ретінде де, сапрофит ретінде де көрсетеді, сол үшін оларды факультативті паразиттер деп атайды. Облигатты паразиттер өздерінің метаболиттік мүмкіндіктерін толығымен жоғалтқаннан кейін қожайын организмдердің ұлпаларын зақымдай отырып тіршілік етеді.

- Іс жүргізу
- Автоматтандыру, Техника
- Алғашқы әскери дайындық
- Астрономия
- Ауыл шаруашылығы
- Банк ісі
- Бизнесті бағалау
- Биология
- Бухгалтерлік іс
- Валеология
- Ветеринария
- География
- Геология, Геофизика, Геодезия
- Дін
- Ет, сүт, шарап өнімдері
- Жалпы тарих
- Жер кадастрі, Жылжымайтын мүлік
- Журналистика
- Информатика
- Кеден ісі
- Маркетинг
- Математика, Геометрия
- Медицина
- Мемлекеттік басқару
- Менеджмент
- Мұнай, Газ
- Мұрағат ісі
- Мәдениеттану
- ОБЖ (Основы безопасности жизнедеятельности)
- Педагогика
- Полиграфия
- Психология
- Салық
- Саясаттану
- Сақтандыру
- Сертификаттау, стандарттау
- Социология, Демография
- Спорт
- Статистика
- Тілтану, Филология
- Тарихи тұлғалар
- Тау-кен ісі
- Транспорт
- Туризм
- Физика
- Философия
- Халықаралық қатынастар
- Химия
- Экология, Қоршаған ортаны қорғау
- Экономика
- Экономикалық география
- Электротехника
- Қазақстан тарихы
- Қаржы
- Құрылыс
- Құқық, Криминалистика
- Әдебиет
- Өнер, музыка
- Өнеркәсіп, Өндіріс
Қазақ тілінде жазылған рефераттар, курстық жұмыстар, дипломдық жұмыстар бойынша біздің қор #1 болып табылады.



Ақпарат
Қосымша
Email: info@stud.kz